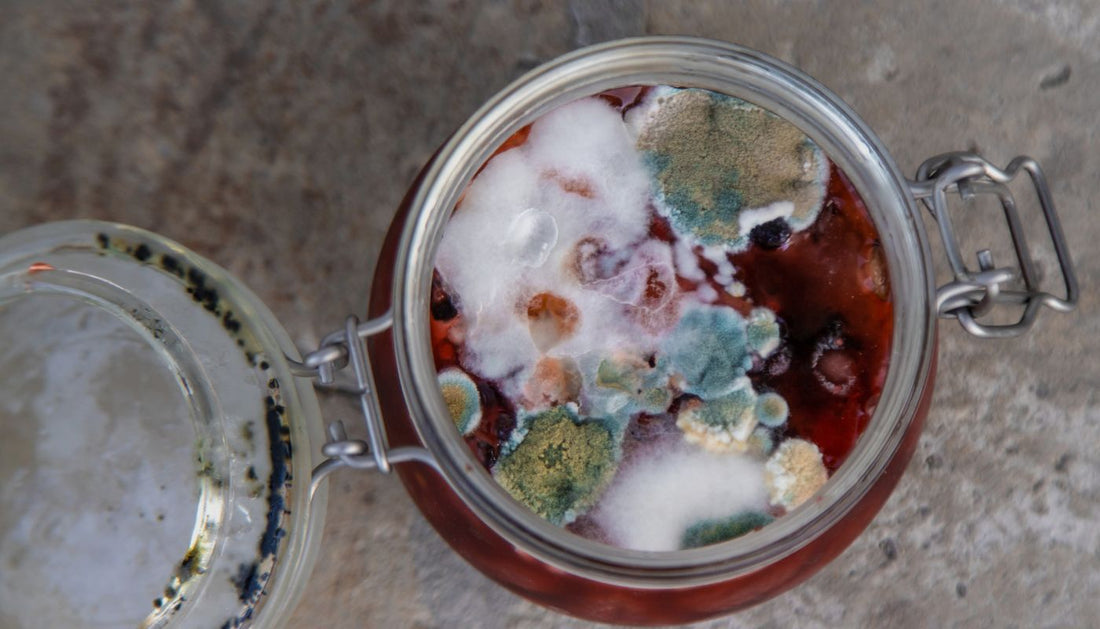

Life gets busy, and sometimes, things slip through the cracks. You've started brewing a batch of kombucha, excitedly anticipating the refreshing, bubbly beverage. Days turned into weeks, and before you knew it, you completely forgot about that jar bubbling away on your countertop! Is your forgotten jar of kombucha now a lost cause? Can kombucha actually ferment for too long?
This blog will shed light on the common issue of over-fermentation. You'll learn to identify when kombucha has over-fermented, understand the factors influencing fermentation time, and explore creative ways to salvage your brew. So, let's ensure your brewing journey is as sparkling as the drink itself!
What is kombucha?
Kombucha is a fermented tea beverage known for its probiotic benefits. It is created by culturing sweetened tea with a SCOBY, a Symbiotic Culture of Bacteria and Yeast. This unique culture transforms simple tea into kombucha through fermentation.
The SCOBY converts sugars into various helpful compounds such as carbon dioxide, alcohol, and acetic and lactic acid. This transformation imparts kombucha with its signature tangy yet slightly sweet flavour, effervescent texture, and generally clear to slightly cloudy appearance.
Kombucha fermentation process
During the fermentation process, the SCOBY kicks into action and breaks down the sugars present in the sweet tea. Here's a detailed breakdown of the process to understand the evolving nature of the drink:
-
Early stage (Day 1-3): In the early stages of fermentation, the yeast within the SCOBY dominates, converting sugar into alcohol. At this point, the tea is still quite sweet. You might notice the SCOBY floating on the tea's surface.
-
Mid-stage (Day 4-7): As fermentation progresses, bacteria in the SCOBY take over, producing acetic acid, which gives kombucha its characteristic tangy flavour. While the initial sweetness begins to wane, a slightly sour taste starts to creep in, signaling the fermentation's progress.
-
Late stage (Day 8-14): The final primary fermentation stage sees most of the sugar consumed by the SCOBY. The kombucha becomes increasingly acidic, reaching its peak tanginess and developing a mature flavour profile that enthusiasts cherish.
-
Secondary fermentation (Optional): After the primary fermentation, some kombucha enthusiasts engage in secondary fermentation. This involves bottling the kombucha with fruit, juices, or other flavourings and allowing it to carbonate further. This stage can add additional complexity to the flavour profile and increase the effervescence.
Having cracked the basics of kombucha, let's see whether it can be left to bubble away for too long!
Can kombucha ferment too long?
The fermentation process gives kombucha its characteristic flavour and probiotic benefits. However, like any fermentation process, there's a sweet spot. If allowed to ferment for an extended period, kombucha can become over-fermented, leading to undesirable changes.
The ideal fermentation time for brewing a one-gallon (4 litres) batch of kombucha is generally 7-21 days. Typically, kombucha achieves the desired point of fermentation within 7-14 days, but climate and temperature can affect this process. In such cases, getting the right balance of sourness and carbonation in kombucha might take longer than expected.
However, brewing beyond the desired point, especially after 21 days, can lead to over-fermentation. The desired point varies depending on personal preference, but generally, it's when the kombucha has reached a pleasantly tart flavour without becoming excessively sour or vinegary. Thus, recognizing when to end fermentation is essential to prevent your brew from turning too tart.
So, how can you tell if your kombucha has crossed the line into over-fermented territory? Let's find out!
Signs of over-fermentation
When you're brewing kombucha, an alluring scent can waft through your kitchen, signaling the transformation of tea and sugar into this fizzy, tangy drink. But how can you tell if your kombucha has fermented for too long? Keep an eye out for these telltale signs:
-
Strong vinegar smell: While a slight vinegar aroma is normal and indicates successful fermentation, an overpowering vinegar scent can be a red flag. Over time, the balance can tip, and your kombucha might smell more like a bottle of vinegar than the fruity and tangy concoction you aimed for.
-
Extremely sour taste: Kombucha should ideally have a balance between sweet and sour, but if you notice it has lost almost all sweetness and has become unpleasantly acidic, it's probably fermented too long. This is because yeast species break down the sugars, forming alcohol and acids, which can overpower if left unchecked.
-
Thick SCOBY growth: The SCOBY plays a vital role in fermentation. While some growth is expected, if you observe that your SCOBY has grown unusually thick or developed multiple layers, your brew might have been left to ferment a bit longer than needed. This visual indicator can signal that it's time to halt the process before it veers too far into vinegary territory.
-
Reduced carbonation: Ideally, kombucha should have a pleasant fizz, a sign of active fermentation. However, an over-fermented batch will exhibit fewer bubbles since much of the fermentation activity has already peaked. This reduced carbonation can leave your drink lacking in the effervescence typically associated with kombucha.
Did you know that bacteria in your gut can affect your sense of smell? Uncover this fascinating fact by watching the video below.
Now that you know the signs, let's dig into what causes kombucha to go overboard!
Also read: Who Needs to Know the Health Benefits of Drinking Kombucha Daily?
Factors affecting kombucha fermentation
There's no single magic number when it comes to kombucha fermentation time. The 7-21 days range is a broad guideline, and the actual time can vary significantly. So, what factors influence how long it takes for your kombucha to reach its peak?
-
Temperature: Kombucha ferments best in a moderately warm environment, ideally between 68-77°F (20-25°C). If the temperature is on the cooler side, you might experience your fermentation time dragging out to 3 to 4 weeks. Conversely, warmer temperatures can speed the process, allowing you to brew in 7-10 days. This is because the bacteria and yeast in the SCOBY thrive in these warm conditions, producing that tangy, effervescent drink more quickly.
-
Sugar content: Sugar is the primary food source for bacteria and yeast, making it critical to fermentation. The typical guideline is to use about 1 cup of sugar per gallon of kombucha. Too little sugar can stall the process because the microorganisms in the SCOBY wouldn't have enough nutrients. In contrast, sufficient amounts allow them to convert sugar into those beloved sour notes efficiently.
-
Vessel size and shape: A vessel with a suitable wide opening ensures good oxygen flow, which is necessary for the bacteria culture. If the vessel is too narrow or sealed tightly, the bacteria can become deprived of oxygen, hindering fermentation. Covering your vessel with a cloth or rag can help maintain airflow while keeping unwanted contaminants at bay.
-
SCOBY health: A larger, robust SCOBY tends to ferment faster due to its higher concentration of bacteria and yeast. However, if it is too old or too thick, with dead layers, it can slow down the process. Occasionally, removing these inactive layers keeps your SCOBY working efficiently. Also, new or refrigerated SCOBYs might start slower but usually pick up speed with repeated use.
-
Starter tea: This tea, sourced from a previous batch, sets the acidic environment necessary for fermentation to proceed effectively. A shortage in starter tea might delay the process, whereas adding an adequate amount—around 2 cups per gallon—ensures a vibrant and swift fermentation.
These factors collectively influence how long your kombucha takes to ferment. Understanding them can help fine-tune your brewing and ensure your kombucha is just how you like it.
Armed with this knowledge, let's explore some handy tips to keep your brew just right!
Tips for preventing kombucha from over-fermenting
You've invested your time and effort in brewing a batch of kombucha. The anticipation of that first refreshing sip is exciting! But what if your kombucha becomes over-fermented, resulting in an overly sour drink? To avoid this, we've got some crucial tips to keep your brew perfectly balanced:
-
Monitor fermentation: Keep a close eye on your kombucha, especially during warmer weather when fermentation can proceed more quickly. A general guideline is to allow your kombucha to ferment for about 7-14 days, but remember that this can vary. Your senses of taste and smell are your best guides. If you notice the flavour becoming too sour, adjust the fermentation period accordingly.
-
Control temperature: The ideal temperature range for fermenting kombucha is between 68-85°F (20-30°C). Temperatures on the higher end can accelerate the process, often leading to an overly tart flavour if left unchecked. By choosing a fermentation spot with a stable, cooler temperature, you can better control the rate at which kombucha ferments.
-
Focus on proper storage: Glass containers are highly recommended for fermenting kombucha. Not only do they prevent contamination, but glass is also non-reactive, helping to preserve the health of the symbiotic culture of bacteria and yeast and ensuring a cleaner taste. It's an investment in quality you won't regret.
-
Use a breathable lid: To allow kombucha to 'breathe' properly during fermentation, use a breathable lid, such as a piece of cheesecloth secured with a rubber band. Proper gas exchange is crucial for healthy fermentation. However, be cautious; the cloth should be tightly woven to prevent airborne contaminants like dust or insects from entering the fermentation vessel.
-
Taste test regularly: By sampling your brew frequently—especially towards the latter part of the fermentation period—you can pinpoint when it reaches the perfect blend of sweet and tart. Don't hesitate to stop the process when you find your perfect flavour balance.
-
Refrigerate timely: Once you've hit that ideal flavour, don't forget to refrigerate your kombucha promptly. Chilling your brew significantly slows down fermentation, preserving acidity and carbonation levels that are just right for your palate. This step ensures your months of brewing effort lead to a delightful, not-too-sour surprise.
But what if your batch has already crossed that line? Don’t worry; there are some nifty ways to make the most out of it!
Creative ways to use over-fermented kombucha
Didn't your first homebrewing session go quite as planned? Don't worry, you're not alone! While drinking over-fermented kombucha may not be the most pleasant experience, it is far from useless. When life gives you sour kombucha, make something extraordinary with these creative uses:
-
Use as a strong starter tea: Overfermented kombucha, with its high concentration of beneficial bacteria and yeast, can be a potent starter tea for a new batch of kombucha. Store it in a glass container, securely sealed, and who knows, your next batch may even ferment a bit faster.
-
Household cleaner: While less conventional, the high acidity of over-fermented kombucha can be used as a potential natural cleaning agent. It works similarly to vinegar. Dilute it with water and use it to clean surfaces like countertops, sinks, and floors.
-
Marinades and dressings: Integrate this tart liquid into your culinary endeavours by using it in marinades for meats. The acidity will tender the meat, allowing your marinade flavours to soak in. You can also craft a zesty salad dressing by mixing it with olive oil, honey, and other typical dressing components.
-
Facial toner: For the skincare aficionados out there, diluted over-fermented kombucha can double as a facial toner. Its acidity can help balance your skin's pH and reduce oiliness. Remember to dilute it properly to avoid irritation, especially if you have sensitive skin. Test it on a small skin patch to ensure it suits your skin type.
-
Substitute for regular vinegar: Cooking or baking? You can use your over-fermented kombucha as a vinegar substitute thanks to its sharp, sour profile. It adds a unique flavour twist to your recipes, whether in vinaigrettes, pickles, soup, sauce, or cakes. Just pick it up like any other bottle of vinegar in your pantry.
-
Add to drinks: If you're not quite ready to give up on drinking your brew, try diluting it with carbonated water, a soft drink, or just plain water. This makes the tartness more manageable. Balance it out with some fruit juice or a bit of honey to make it sweeter and more refreshing. Even without a second fermentation, you can enjoy a toned-down version of your initial concoction.
-
Kombucha mayonnaise: Believe it or not, you can use over-fermented kombucha to make a healthy and unique mayonnaise! Blend over-fermented kombucha with oil (like avocado oil) and a touch of mustard to create a tangy and flavourful mayonnaise. Kombucha mayo is sure to go with your favourite salad or sandwich.
Fermentation is at the core of kombucha brewing, transforming simple sweet tea into a flavourful, probiotic-rich beverage. Striking the right balance is essential, however, as excessive fermentation can spoil the fun—and the flavour.
But take comfort in the fact that even if kombucha can ferment for too long, it's not a lost cause. Embrace the tang and turn it into something useful; your household and taste buds might thank you.
Do you want to enjoy the refreshing taste of expertly fermented kombucha without the hassle of brewing? The Good Bug offers a delectable range of kombucha drinks crafted with care, ensuring every sip is a delightful experience. Visit our website for additional tips, tricks, and resources to enhance your kombucha brewing experience. Embrace this adventure and happy brewing!
References
https://www.kombuchakamp.com/fermentation-time
https://culturesforhealth.com/blogs/learn/blog-sometimes-blow-fermented-kombucha
https://brewbuch.com/kombucha-too-vinegary/
https://www.everythingkombucha.com/post/why-your-kombucha-is-taking-a-long-time-to-ferment
https://www.culturedfoodlife.com/10-ways-to-use-your-over-fermented-kombucha/